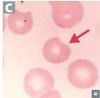

Associated Diseases and Cell Types/Names Flashcards
(25 cards)
Associated Disease?

Lead Poisoning
Associated Disease?
G6PD Deficency
Cell Type / Name?

Degmacyte “Bite Cells”
Associated Disease?

Hereditary Elliptocytosis
Cell Type / Name?

Elliptocyte
Associated Diseases?
There are two

Megaloblastic Anemia (also see hypersegmented PMNs)
Marrow Failure
Cell Type / Name?

Macro-ovalocyte
Associated Disease?

Siderblastic Anemia
Name what the “blue dots” represent and where are they found in the cell?

Excess Iron in the mitrochondria
Cell Type / Name?

Ringed Sideroblast
Diseases Associated? (3)
Other cause? (1)

Diseases: DIC, TTP/HUS, HELLP
Other causes: Mechanical hemolysis (heart valve prosthesis)
Cell Name / Type?

Schistocyte (Helmet cell)
Associated Disease?

Sickle Cell Anemia / SCD
What exacerbates this disease forming more of these cells?

Dehydration
Deoxygenation
high altitude
stress (metabolic, sepsis, etc)
Cell Name?

Sickle Cell
Associated Diseases? (2)

Hereditary spherocytosis
Hemolytic anemia d/t drug and/or infection induced
Cell Name?

Spherocyte
Associated Pathology?

Bone Marrow Infiltration - myelofibrosis
Cell Type/Name?

Dacrocyte (Teardrop cell)
Associated Diseases? (4)

Hbc
Asplenia
Liver dz
Thalassemia
Cell Type/ Name?

Target cell
Diseases associated? (2)

G6PD Deficiency
Heinz-body like inclusions seen in a-thalassemia
Name of the inclusion bodies?
What substance is inside?

Heinz Bodies
precipitated Hb
What is the pathway/process these inclusion bodies occur?

Oxidation of Hb-SH groups to S-S lead to Hb precipitation